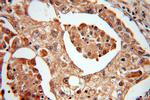
MTH1 Antibody in Immunohistochemistry (Paraffin) (IHC (P))

Search
Proteintech
MTH1 Polyclonal Antibody
{{$productOrderCtrl.translations['antibody.pdp.commerceCard.promotion.promotions']}}
{{$productOrderCtrl.translations['antibody.pdp.commerceCard.promotion.viewpromo']}}
{{$productOrderCtrl.translations['antibody.pdp.commerceCard.promotion.promocode']}}: {{promo.promoCode}} {{promo.promoTitle}} {{promo.promoDescription}}. {{$productOrderCtrl.translations['antibody.pdp.commerceCard.promotion.learnmore']}}
产品信息
16705-1-AP
种属反应
已发表种属
宿主/亚型
分类
类型
抗原
偶联物
形式
浓度
规格
纯化类型
保存液
内含物
保存条件
运输条件
产品详细信息
Immunogen sequence: MSGISPQQM GEPEGSWSGK NPGTMGASRL YTLVLVLQPQ RVLLGMKKRG FGAGRWNGFG GKVQEGETIE DGARRELQEE SGLTVDALHK VGQIVFEFVG EPELMDVHVF CTDSIQGTPV ESDEMRPCWF QLDQIPFKDM WPDDSYWFPL LLQKKKFHGY FKFQGQDTIL DYTLREVDTV (19-197 aa encoded by BC014618)
靶标信息
Oxygen radicals damage chromosomal DNA causing cell death and inducing mutations. Among the various classes of DNA damage caused by oxygen radicals, an oxidized form of guanine base (8-oxoguanine) appears to be important as it can pair with cytosine and adenine and G:C to T:A transversion mutation occurs. A significant amount of 8-OxoG is formed in the chromosomal DNA of mammalian cells, with most damaged nucleotides excised from the DNA and excreted in the urine. Along with 8-oxoG being present in oxidatively damaged DNA, 8-oxo-deoxyguanosine (8-oxo-dGTP) is formed in the nucleotide pool during normal cellular metabolism and following oxidative stress. The 8-oxo-dGTP nucleotide can be incorporated in DNA during polymerization and can result in a mispairing unless repaired. MTH converts 8-oxo-dGTP in the nucleotide pool to the monophosphate and prevents the misincorporation of 8-oxo-dGTP into DNA (Figure courtesy of Dr. Mark Kelley). MTH also recognizes 8-oxo-rGTP, which could incorporate into RNA during gene transcription leading to missense or nonsense protein production.
仅用于科研。不用于诊断过程。未经明确授权不得转售。
生物信息学
蛋白别名: 2-hydroxy-dATP diphosphatase; 7,8-dihydro-8-oxoguanine triphosphatase; 8-oxo-7,8-dihydro-2'-dGTPase; 8-oxo-7,8-dihydrodeoxyguanosine triphosphatase; 8-oxo-7,8-dihydroguanosine triphosphatase; 8-oxo-dGTPase; Methylated purine nucleoside triphosphate hydrolase; mutT human homolog (8-oxo-dGTPase); mutT human homolog 1; Nucleoside diphosphate-linked moiety X motif 1; nucleoside diphosphate-linked moiety X-type motif 1; nudix (nucleoside diphosphate linked moiety X)-type motif 1; Nudix motif 1; nudix-type motif 1; NUDT1; Oxidized purine nucleoside triphosphate hydrolase
基因别名: MTH1; NUDT1
UniProt ID: (Human) P36639, (Rat) P53369, (Mouse) P53368
Entrez Gene ID: (Human) 4521, (Rat) 117260, (Mouse) 17766